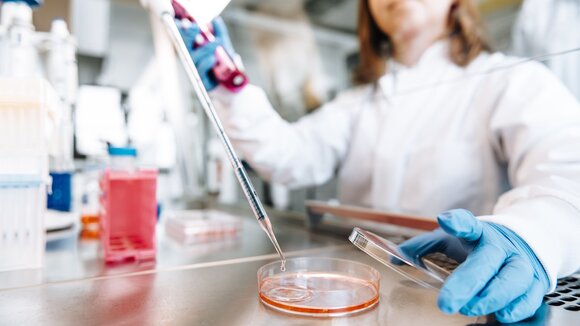
ASC Oncology beantwortet dank Testverfahren die zentrale Frage nach der Wirksamkeit von Krebsmedikamenten am Patiententumor

Pressemitteilung/press release
ASC Oncology beantwortet dank Testverfahren die zentrale Frage nach der Wirksamkeit von Krebsmedikamenten am Patiententumor
Berlin, 26.1.2021 – Bei rund der Hälfte aller Krebspatienten weltweit versagt die verschriebene Chemotherapie. ASC Oncology stellt sich mit dem Reverse Clinical Engineering-Testverfahren dieser Herausforderung der Krebsbehandlung und trifft wissenschaftlich belastbare Aussagen über die Wahrscheinlichkeit der Wirkung sowie Nicht-Wirkung von…